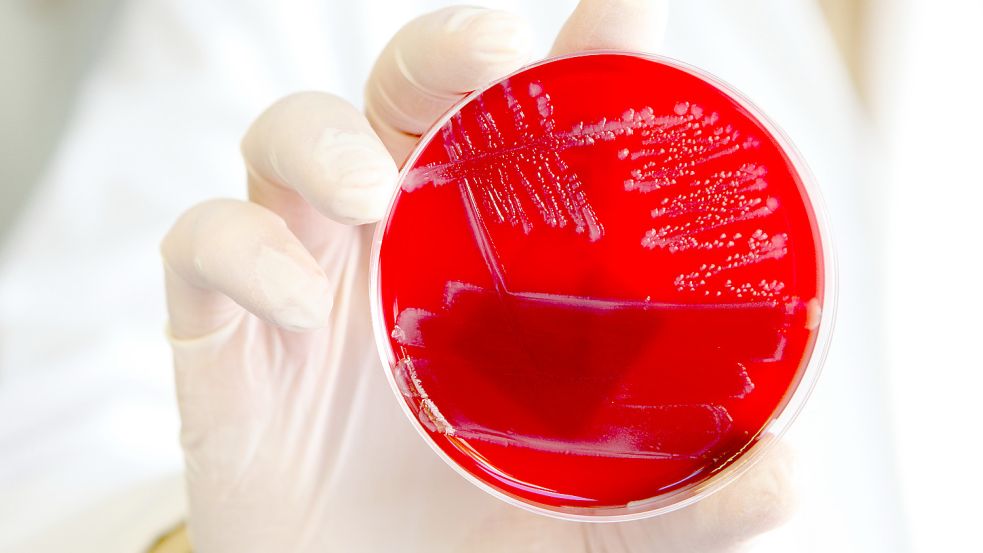

Hamburg
Wirkungslose Antibiotika: An diesen Alternativen arbeiten Forscher

Wenn Bakterien rot sehen: Weil immer mehr von ihnen unempfindlich auf Antibiotika reagieren und diese wirkungslos werden, arbeiten Forscher an Alternativen. Foto: dpa / Bodo Marks
Jährlich erkranken in Deutschland Zehntausende Menschen an Keimen, gegen die Antibiotika nicht mehr richtig wirken. Viele sterben. Im Interview erklärt der Chemiker Mark Brönstrup, an welchen Lösungen Forscher arbeiten.
Lesedauer des Artikels: ca. 4 Minuten
Jetzt Artikel freischalten
Schnell bestellt – jederzeit kündbar.
- Voller Zugriff auf www.oz-online.de
- 700+ neue Artikel pro Woche
- OZ-App inklusive
3 Monate je
1€
statt 9,90 €
Du hast bereits ein OZ-Abo? Super!
Weitere Abo-Modelle